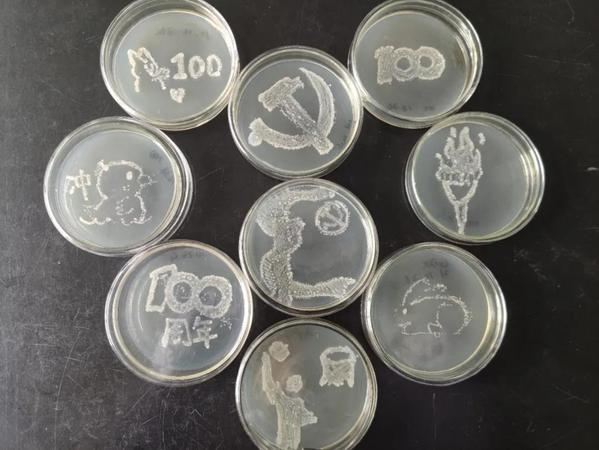

“我们生在红旗下,长在春风里,目光所至,皆为华夏,五星闪耀,皆为信仰。”为积极响应党的号召,弘扬伟大建党精神,10月26日,在公司专业兴趣党小组的指导下,学院畜禽传染病兴趣小组组长黎佳杰带领小组成员积极参与建党百年献礼活动,以菌液为“墨”,接种环为“笔”,培养基为“画板”,通过画平皿的方式将专业知识与党史内容相结合,将党史美好的画卷跃然“皿”上,以表达对建党一百周年的美好祝愿。
活动结束后,黎佳杰主持党史知识竞答活动,大家踊跃回答问题,场面十分热烈。

供稿:畜禽传染病兴趣小组 编辑:裘晨 审核:陈小志
